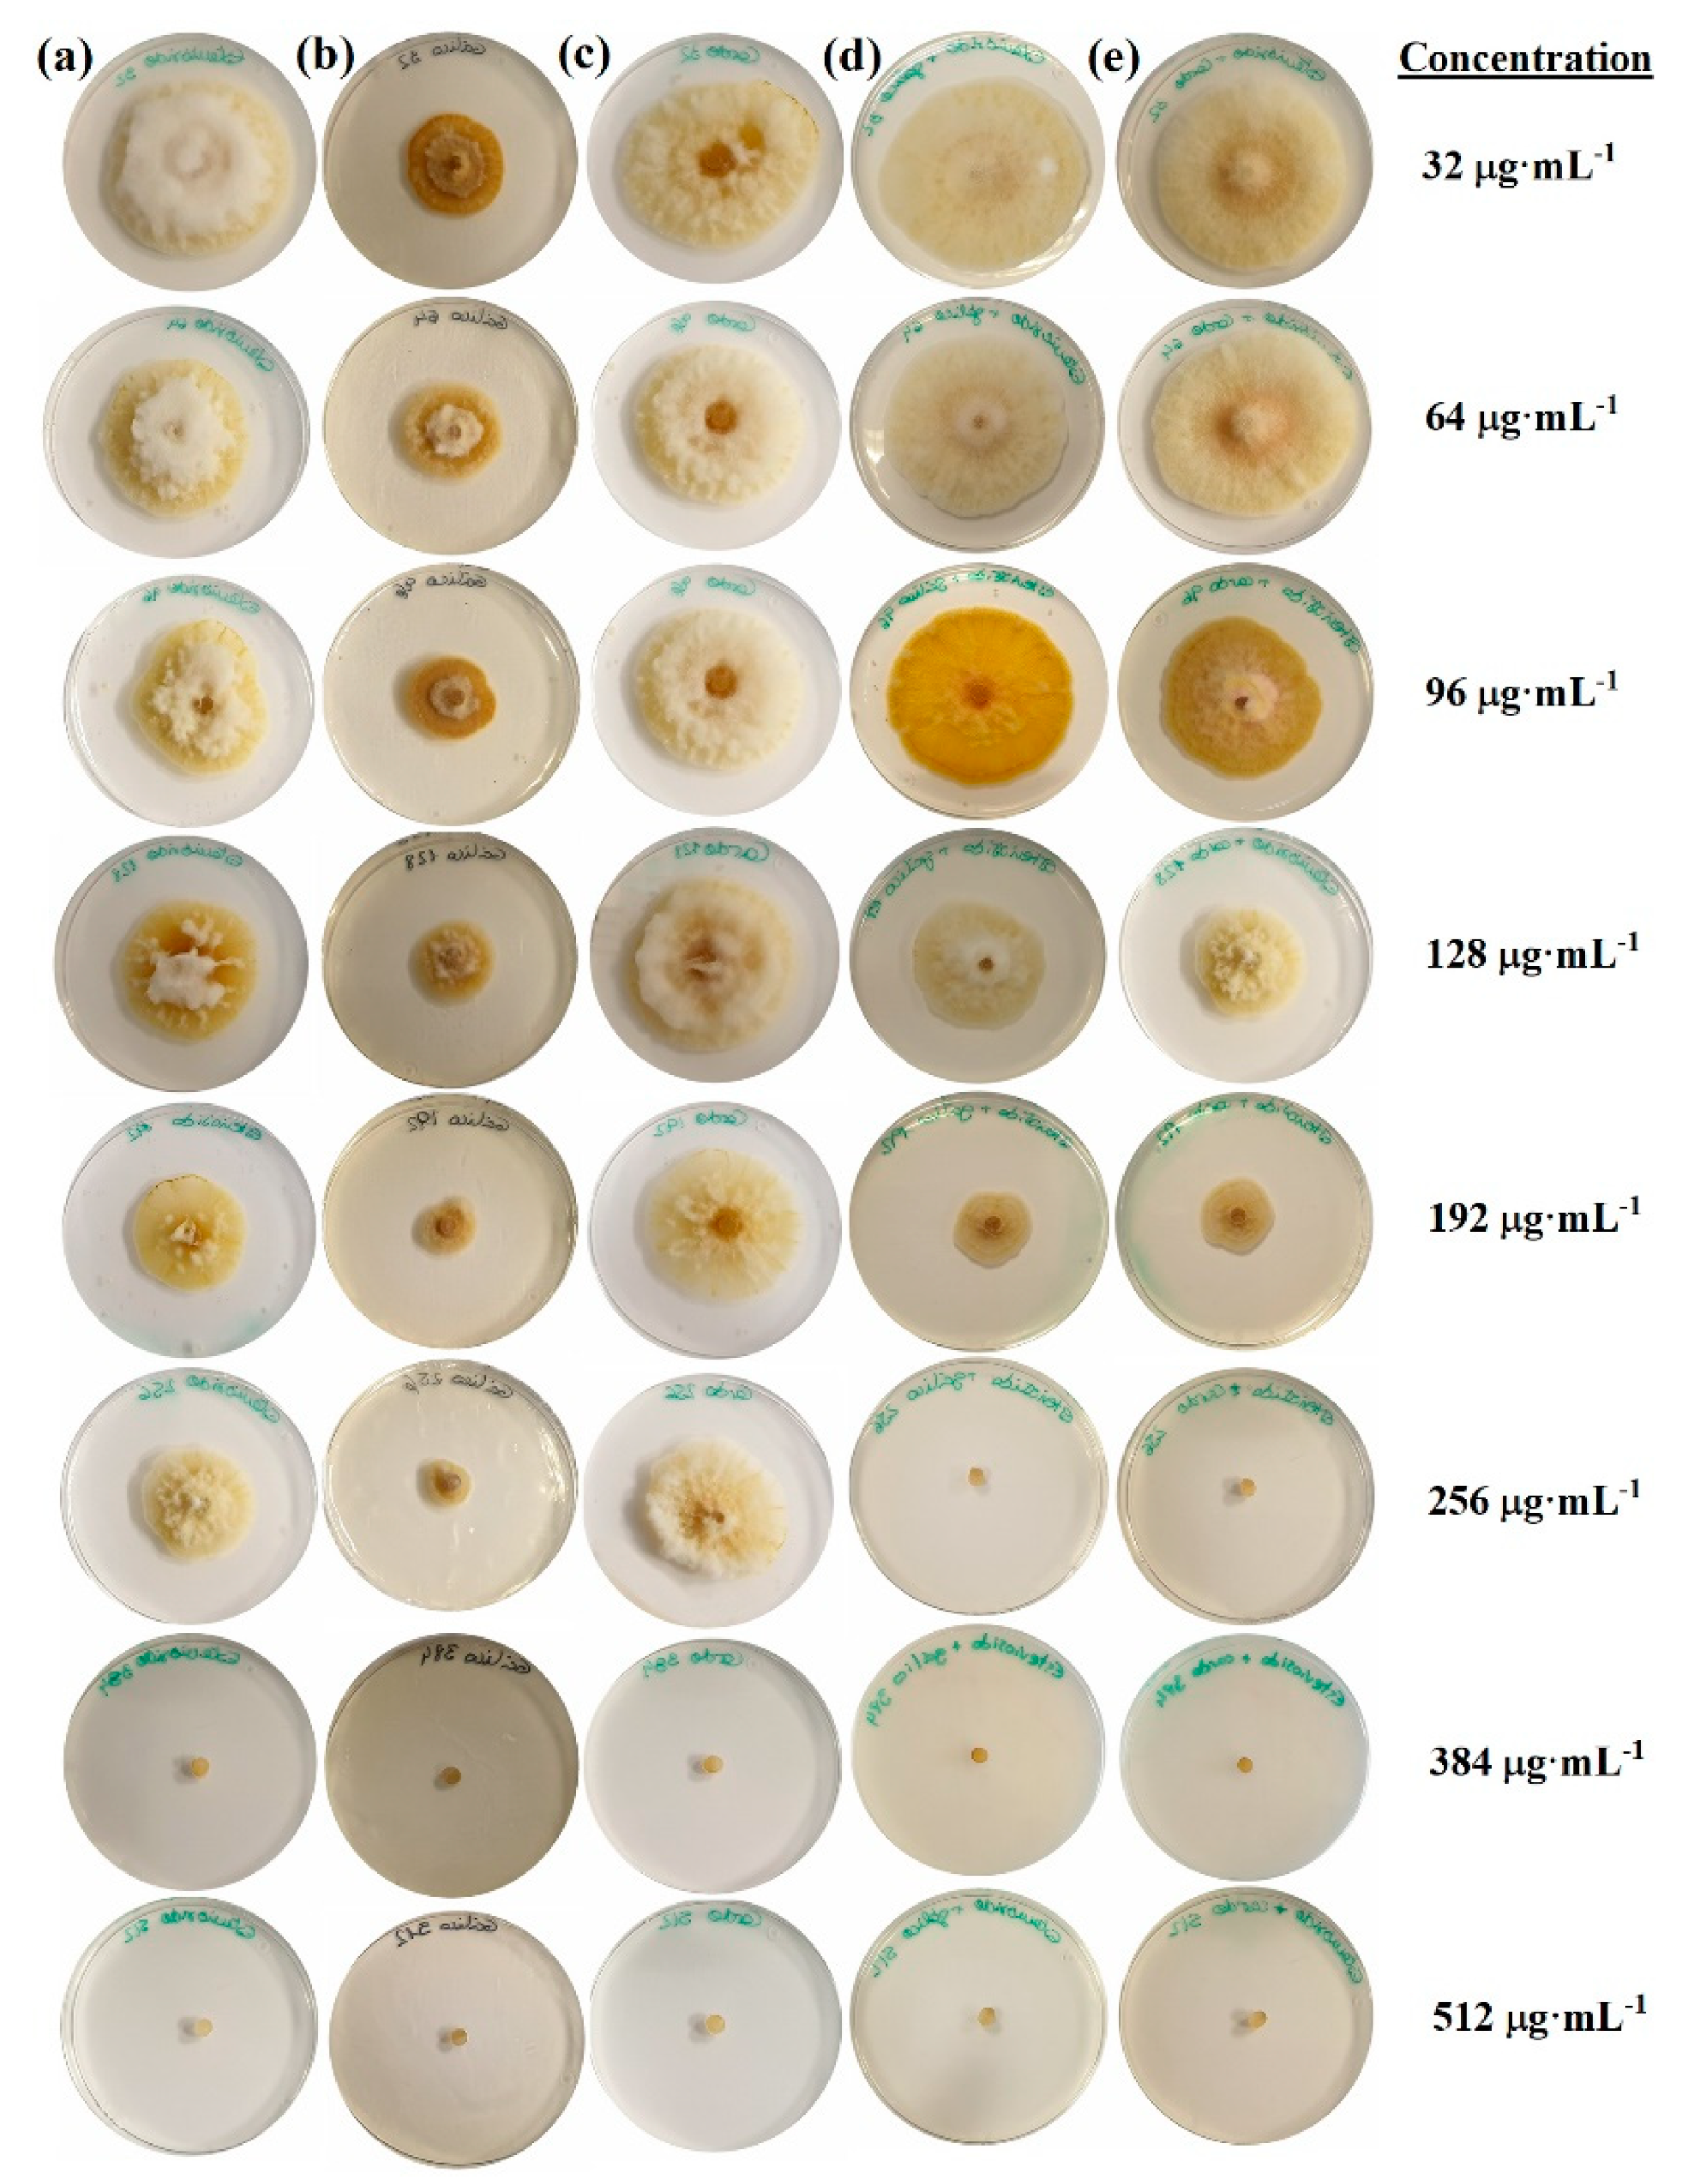
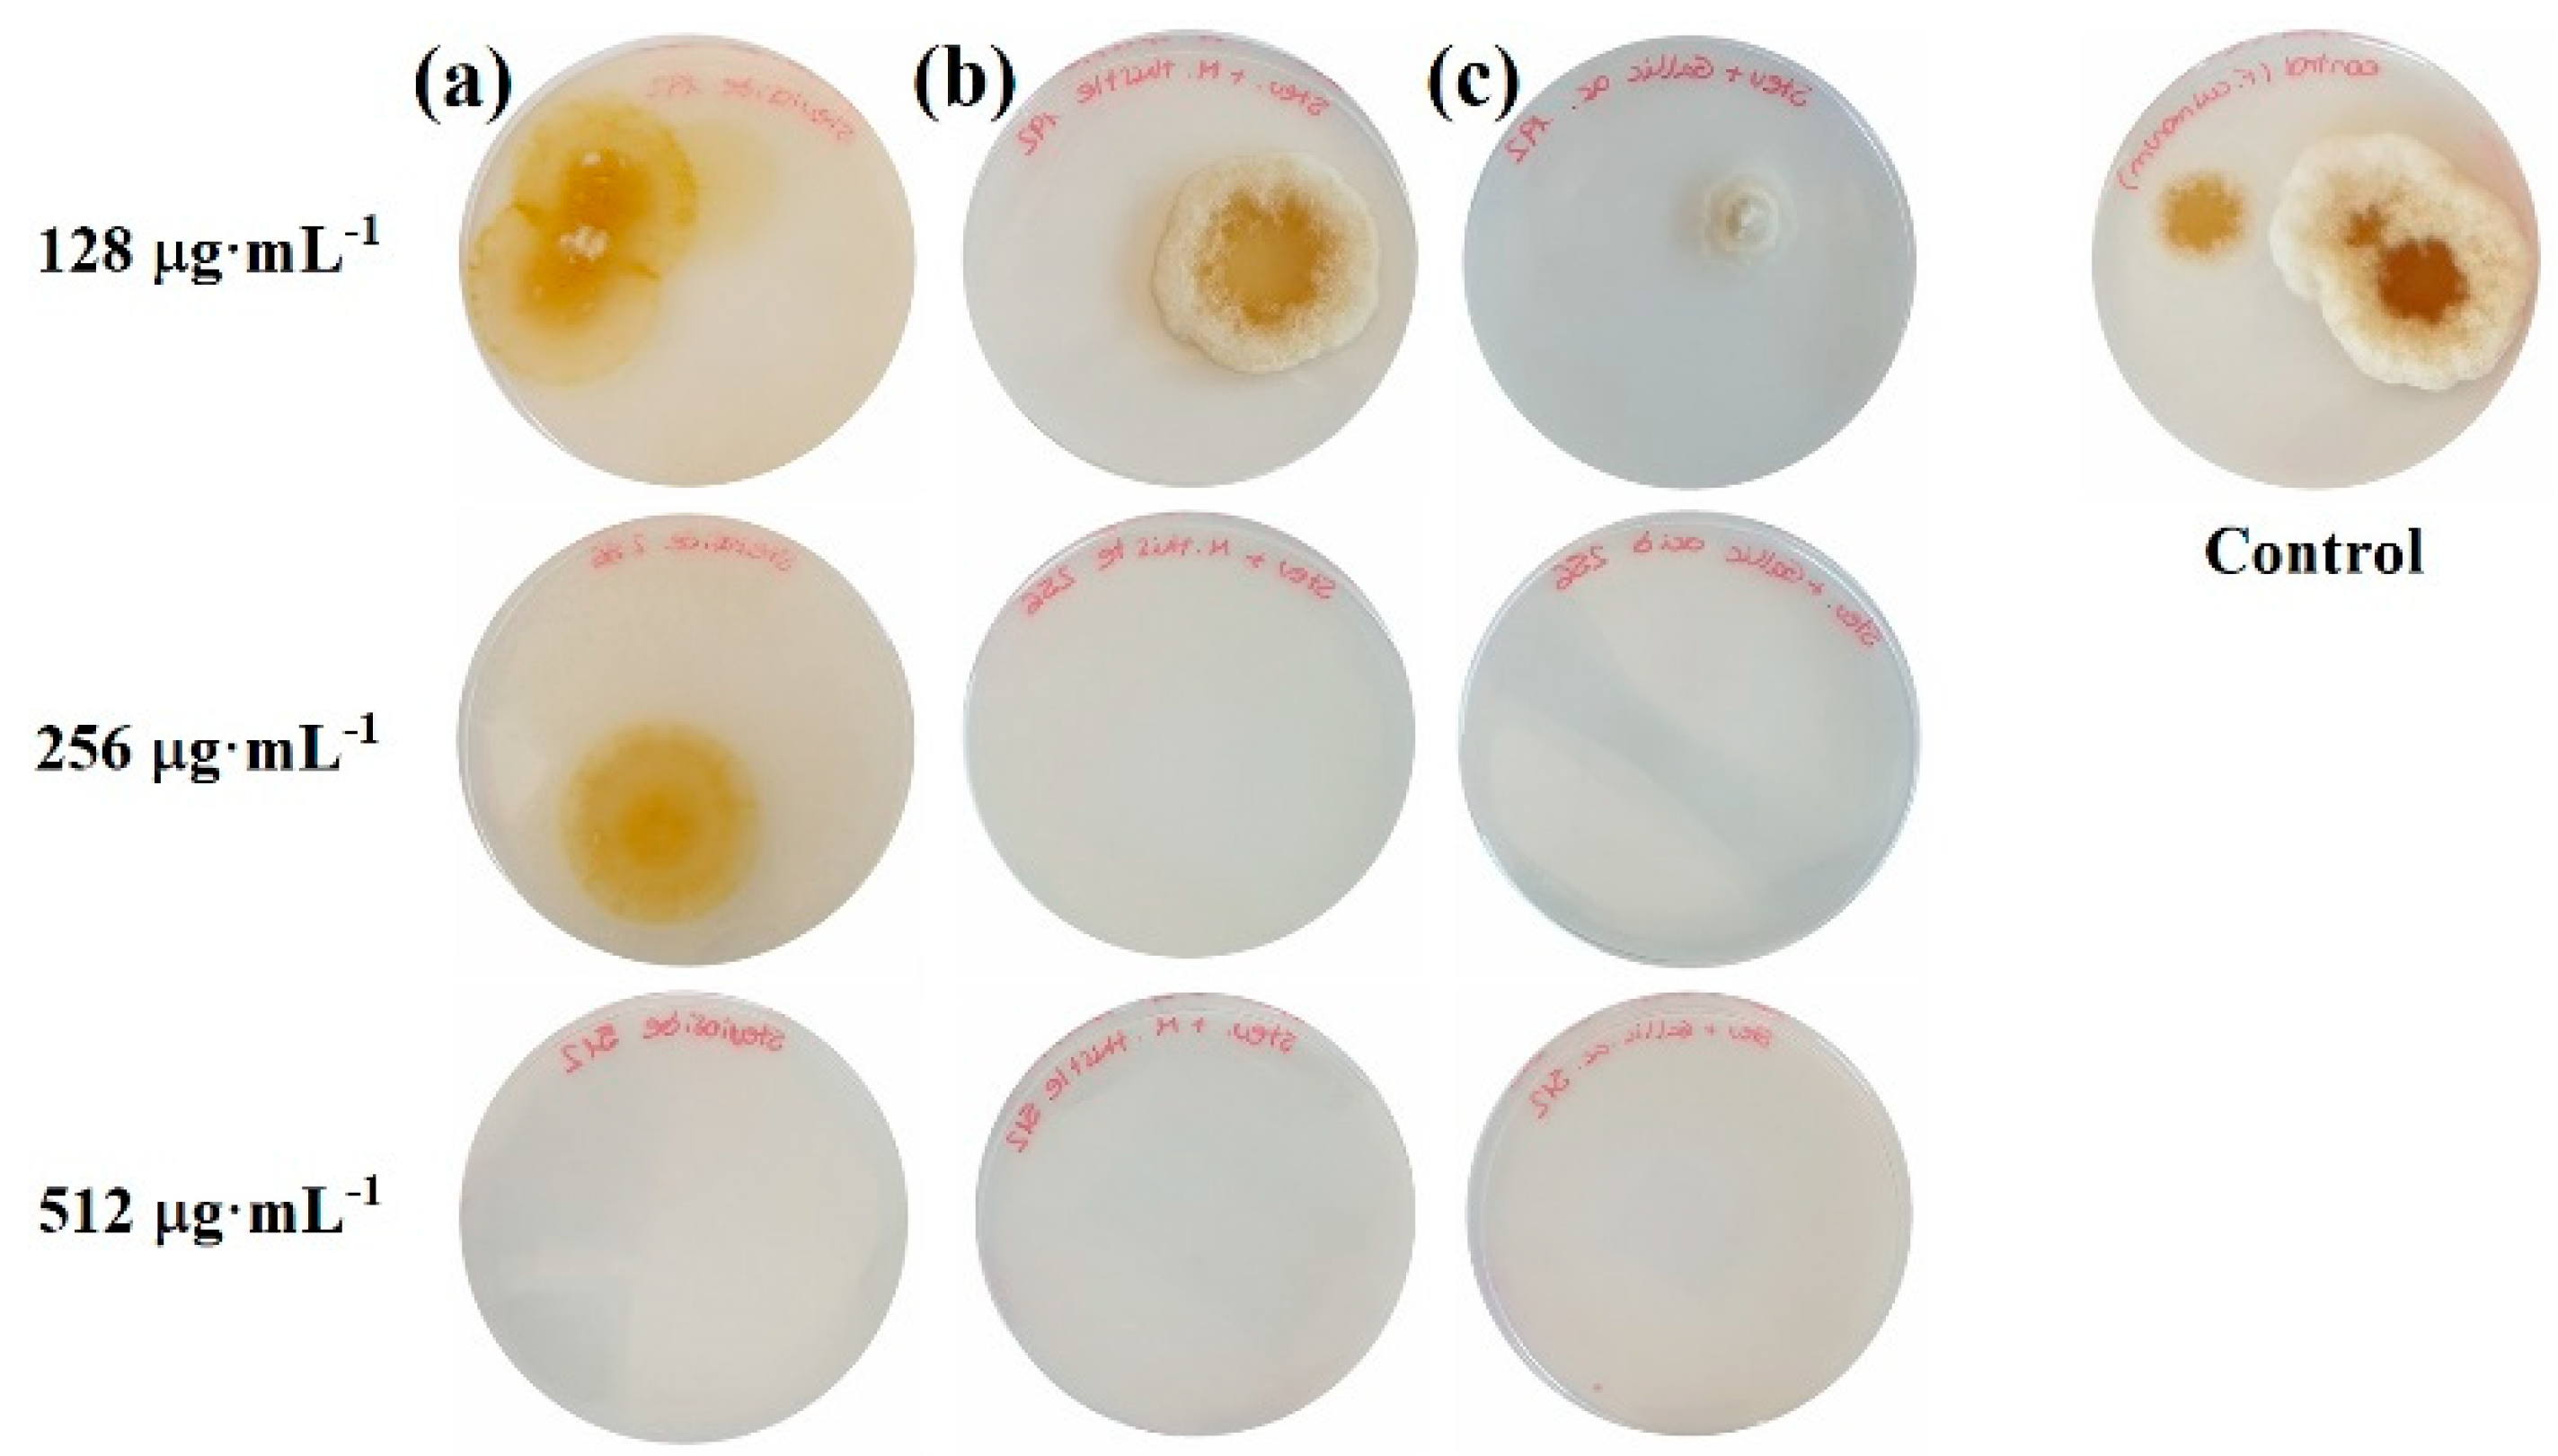

Antifungal Activity against Fusarium culmorum of Stevioside, Silybum marianum Seed Extracts, and Their Conjugate Complexes
Abstract
1. Introduction
2. Results
2.1. Sensitivity Tests
2.2. Effect of the Stevioside−S. marianum Seed Extract Conjugate Complex on Deoxynivalenol Production
2.3. Seedling Tests
3. Discussion
3.1. Efficacy of the Treatments
3.2. Mechanism of Action
4. Materials and Methods
4.1. Reagents and Fungal Isolate
4.2. Preparation of the Bioactive Solutions
4.3. In Vitro Tests of Mycelial Growth Inhibition
4.4. Preparation of Inoculum and Inhibition of Colonies Formation
4.5. Effect of Conjugate Complex on DON Production and DON Determination
4.6. Seedling Tests
4.7. Statistical Analyses
5. Conclusions
6. Patents
Author Contributions
Funding
Acknowledgments
Conflicts of Interest
References
- Dubey, N.K. Natural Products in Plant Pest Management; CABI: Oxfordshire, UK; Cambridge, MA, USA, 2011; p. 293. [Google Scholar]
- Momtazi-Borojeni, A.A.; Esmaeili, S.-A.; Abdollahi, E.; Sahebkar, A. A review on the pharmacology and toxicology of steviol glycosides extracted from Stevia rebaudiana. Curr. Pharm. Des. 2017, 23, 1616–1622. [Google Scholar] [CrossRef] [PubMed]
- Bursać Kovačević, D.; Maras, M.; Barba, F.J.; Granato, D.; Roohinejad, S.; Mallikarjunan, K.; Montesano, D.; Lorenzo, J.M.; Putnik, P. Innovative technologies for the recovery of phytochemicals from Stevia rebaudiana Bertoni leaves: A review. Food Chem. 2018, 268, 513–521. [Google Scholar] [CrossRef] [PubMed]
- Ruiz-Ruiz, J.C.; Moguel-Ordoñez, Y.B.; Segura-Campos, M.R. Biological activity of Stevia rebaudiana Bertoni and their relationship to health. Crit. Rev. Food Sci. Nutr. 2015, 57, 2680–2690. [Google Scholar] [CrossRef] [PubMed]
- Kurek, J.M.; Krejpcio, Z. The functional and health-promoting properties of Stevia rebaudiana Bertoni and its glycosides with special focus on the antidiabetic potential—A review. J. Funct. Foods 2019, 61, 103465. [Google Scholar] [CrossRef]
- Salehi, B.; López, M.D.; Martínez-López, S.; Victoriano, M.; Sharifi-Rad, J.; Martorell, M.F.; Rodrigues, C.; Martins, N. Stevia rebaudiana Bertoni bioactive effects: From in vivo to clinical trials towards future therapeutic approaches. Phytother. Res. 2019, 33, 2904–2917. [Google Scholar] [CrossRef] [PubMed]
- Pina-Pérez, M.C.; Rivas, A.; Martínez, A.; Rodrigo, D. Effect of thermal treatment, microwave, and pulsed electric field processing on the antimicrobial potential of açaí (Euterpe oleracea), stevia (Stevia rebaudiana Bertoni), and ginseng (Panax quinquefolius L.) extracts. Food Control 2018, 90, 98–104. [Google Scholar] [CrossRef]
- Kumari, M.; Chandra, S. Stevioside glycosides from in vitro cultures of Stevia rebaudiana and antimicrobial assay. Braz. J. Bot. 2015, 38, 761–770. [Google Scholar] [CrossRef]
- Singh, D.P.; Kumari, M.; Prakash, H.G.; Rao, G.P.; Solomon, S. Phytochemical and pharmacological importance of stevia: A calorie-free natural sweetener. Sugar Tech. 2019, 21, 227–234. [Google Scholar] [CrossRef]
- Shekhawat, G.S.; Mathur, S.; Bulchandan, N.; Parihar, S. Critical review on steviol glycosides: Pharmacological, toxicological and therapeutic aspects of high potency zero caloric sweetener. Int. J. Pharmacol. 2017, 13, 916–928. [Google Scholar] [CrossRef]
- Garcia, D.; Ramos, A.J.; Sanchis, V.; Marín, S. Effect of Equisetum arvense and Stevia rebaudiana extracts on growth and mycotoxin production by Aspergillus flavus and Fusarium verticillioides in maize seeds as affected by water activity. Int. J. Food Microbiol. 2012, 153, 21–27. [Google Scholar] [CrossRef]
- Muanda, F.N.; Soulimani, R.; Diop, B.; Dicko, A. Study on chemical composition and biological activities of essential oil and extracts from Stevia rebaudiana Bertoni leaves. LWT Food Sci. Technol. 2011, 44, 1865–1872. [Google Scholar] [CrossRef]
- Garcia, D.; Garcia-Cela, E.; Ramos, A.J.; Sanchis, V.; Marín, S. Mould growth and mycotoxin production as affected by Equisetum arvense and Stevia rebaudiana extracts. Food Control 2011, 22, 1378–1384. [Google Scholar] [CrossRef]
- Ullah, A.; Munir, S.; Mabkhot, Y.; Badshah, S. Bioactivity profile of the diterpene isosteviol and its derivatives. Molecules 2019, 24, 678. [Google Scholar] [CrossRef] [PubMed]
- Shukla, S.; Mehta, A.; Bajpai, V.K. Phytochemical screening and anthelmintic and antifungal activities of leaf extracts of Stevia rebaudiana. J. Biol. Act. Prod. Nat. 2013, 3, 56–63. [Google Scholar]
- Ramírez, P.G.; Ramírez, D.G.; Mejía, E.Z.; Ocampo, S.A.; Díaz, C.N.; Rojas Martínez, R.I. Extracts of Stevia rebaudiana against Fusarium oxysporum associated with tomato cultivation. Sci. Hortic. 2020, 259, 108683. [Google Scholar] [CrossRef]
- Pani, G.; Scherm, B.; Azara, E.; Balmas, V.; Jahanshiri, Z.; Carta, P.; Fabbri, D.; Dettori, M.A.; Fadda, A.; Dessì, A.; et al. Natural and natural-like phenolic inhibitors of type B trichothecene in vitro production by the wheat (Triticum sp.) pathogen Fusarium culmorum. J. Agric. Food. Chem. 2014, 62, 4969–4978. [Google Scholar] [CrossRef]
- Hussain, Z.; Thu, H.E.; Amjad, M.W.; Hussain, F.; Ahmed, T.A.; Khan, S. Exploring recent developments to improve antioxidant, anti-inflammatory and antimicrobial efficacy of curcumin: A review of new trends and future perspectives. Mater. Sci. Eng. C 2017, 77, 1316–1326. [Google Scholar] [CrossRef]
- Nguyen, T.T.H.; Si, J.; Kang, C.; Chung, B.; Chung, D.; Kim, D. Facile preparation of water soluble curcuminoids extracted from turmeric (Curcuma longa L.) powder by using steviol glucosides. Food Chem. 2017, 214, 366–373. [Google Scholar] [CrossRef]
- Matei, P.; Iacomi, B.; Martín-Gil, J.; Pérez-Lebeña, E.; Ramos-Sánchez, M.; Barrio-Arredondo, M.; Martín-Ramos, P. In vitro antifungal activity of composites of AgNPs and polyphenol inclusion compounds against Fusarium culmorum in different dispersion media. Agronomy 2018, 8, 239. [Google Scholar] [CrossRef]
- Leslie, J.F.; Summerell, B.A. The Fusarium Laboratory Manual, 1st ed.; Blackwell Pub.: Ames, IA, USA, 2006; p. xii. 388p. [Google Scholar]
- Figueroa, M.; Hammond-Kosack, K.E.; Solomon, P.S. A review of wheat diseases-a field perspective. Mol. Plant Pathol. 2018, 19, 1523–1536. [Google Scholar]
- Mishra, S.; Srivastava, S.; Dewangan, J.; Divakar, A.; Kumar Rath, S. Global occurrence of deoxynivalenol in food commodities and exposure risk assessment in humans in the last decade: A survey. Crit. Rev. Food Sci. Nutr. 2019, 60, 1346–1374. [Google Scholar] [CrossRef]
- Khaneghah, A.M.; Martins, L.M.; von Hertwig, A.M.; Bertoldo, R.; Sant’Ana, A.S. Deoxynivalenol and its masked forms: Characteristics, incidence, control and fate during wheat and wheat based products processing—A review. Trends Food Sci. Technol. 2018, 71, 13–24. [Google Scholar] [CrossRef]
- Mhamdi, B.; Abbassi, F.; Smaoui, A.; Abdelly, C.; Marzouk, B. Fatty acids, essential oil and phenolics composition of Silybum marianum seeds and their antioxidant activities. Pak. J. Pharm. Sci. 2016, 29, 953–959. [Google Scholar]
- Balouiri, M.; Sadiki, M.; Ibnsouda, S.K. Methods for vitro evaluating antimicrobial activity: A review. J. Pharm. Anal. 2016, 6, 71–79. [Google Scholar] [CrossRef] [PubMed]
- Petrikkou, E.; Rodriguez-Tudela, J.L.; Cuenca-Estrella, M.; Gomez, A.; Molleja, A.; Mellado, E. Inoculum standardization for antifungal susceptibility testing of filamentous fungi pathogenic for humans. J. Clin. Microbiol. 2001, 39, 1345–1347. [Google Scholar] [CrossRef] [PubMed]
- Wadley, F.M. The Evidence Required to Show Synergistic Action of Insecticides and a Short Cut in Analysis; U.S. Government Printing Office: Washington, DC, USA, 1945.
- Bajpai, V.K.; Kim, H.R.; Hou, C.T.; Kang, S.C. Microbial conversion and in vitro and in vivo antifungal assessment of bioconverted docosahexaenoic acid (bDHA) used against agricultural plant pathogenic fungi. J. Ind. Microbiol. Biotechnol. 2009, 36, 695–704. [Google Scholar] [CrossRef]
- Nguyen, D.-M.-C.; Seo, D.-J.; Lee, H.-B.; Kim, I.-S.; Kim, K.-Y.; Park, R.-D.; Jung, W.-J. Antifungal activity of gallic acid purified from Terminalia nigrovenulosa bark against Fusarium solani. Microb. Pathog. 2013, 56, 8–15. [Google Scholar] [CrossRef]
- Al-Hatmi, A.; Curfs-Breuker, I.; de Hoog, G.; Meis, J.; Verweij, P. Antifungal susceptibility testing of Fusarium: A practical approach. J. Fungi 2017, 3, 19. [Google Scholar] [CrossRef]
- Gao, T.; Bian, R.; Joseph, S.; Taherymoosavi, S.; Mitchell, D.R.G.; Munroe, P.; Xu, J.; Shi, J. Wheat straw vinegar: A more cost-effective solution than chemical fungicides for sustainable wheat plant protection. Sci. Total Environ. 2020, 725, 138359. [Google Scholar] [CrossRef]
- Scaglioni, P.T.; Scarpino, V.; Marinaccio, F.; Vanara, F.; Furlong, E.B.; Blandino, M. Impact of microalgal phenolic extracts on the control of Fusarium graminearum and deoxynivalenol contamination in wheat. World Mycotoxin J. 2019, 12, 367–378. [Google Scholar] [CrossRef]
- Perczak, A.; Gwiazdowska, D.; Marchwińska, K.; Juś, K.; Gwiazdowski, R.; Waśkiewicz, A. Antifungal activity of selected essential oils against Fusarium culmorum and F. graminearum and their secondary metabolites in wheat seeds. Arch. Microbiol. 2019, 201, 1085–1097. [Google Scholar] [CrossRef] [PubMed]
- Wiwart, M.; Suchowilska, E.; Kandler, W.; Sulyok, M.; Wachowska, U.; Krska, R. The response of selected Triticum spp. genotypes with different ploidy levels to head blight caused by Fusarium culmorum (W.G.Smith) Sacc. Toxins 2016, 8, 112. [Google Scholar] [CrossRef] [PubMed]
- Orzali, L.; Forni, C.; Riccioni, L. Effect of chitosan seed treatment as elicitor of resistance to Fusarium graminearum in wheat. Seed Sci. Technol. 2014, 42, 132–149. [Google Scholar] [CrossRef]
- Hu, Y.; Zhang, J.; Kong, W.; Zhao, G.; Yang, M. Mechanisms of antifungal and anti-aflatoxigenic properties of essential oil derived from turmeric (Curcuma longa L.) on Aspergillus flavus. Food Chem. 2017, 220, 1–8. [Google Scholar] [CrossRef]
- Badhani, B.; Sharma, N.; Kakkar, R. Gallic acid: A versatile antioxidant with promising therapeutic and industrial applications. RSC Adv. 2015, 5, 27540–27557. [Google Scholar] [CrossRef]
- Yun, D.G.; Lee, D.G. Silymarin exerts antifungal effects via membrane-targeted mode of action by increasing permeability and inducing oxidative stress. Biochim. Biophys. Acta 2017, 1859, 467–474. [Google Scholar] [CrossRef]
- Yun, D.G.; Lee, D.G. Assessment of silibinin as a potential antifungal agent and investigation of its mechanism of action. IUBMB Life 2017, 69, 631–637. [Google Scholar] [CrossRef]
- Aḥmad, I.L.; Aqil, F.; Owais, M. Modern Phytomedicine: Turning Medical Plants into Drugs; Wiley-VCH: Weinheim, German, 2006; p. 384. [Google Scholar]
- De Oliveira, B. Biotransformation of the diperpenoid, isosteviol, by Aspergillus niger, Penicillium chrysogenum and Rhizopus arrhizus. Phytochemistry 1999, 51, 737–741. [Google Scholar] [CrossRef]
- Chang, S.-F.; Yang, L.-M.; Lo, C.-H.; Liaw, J.-H.; Wang, L.-H.; Lin, S.-J. Microbial transformation of isosteviol and bioactivities against the glucocorticoid/androgen response elements. J. Nat. Prod. 2008, 71, 87–92. [Google Scholar] [CrossRef] [PubMed]
- Cotoras, M.; Folch, C.; Mendoza, L. Characterization of the antifungal activity on Botrytis cinerea of the natural diterpenoids kaurenoic acid and 3β-hydroxy-kaurenoic acid. J. Agric. Food Chem. 2004, 52, 2821–2826. [Google Scholar] [CrossRef] [PubMed]
- De Oliveira, B.H.; Strapasson, R.A. Biotransformation of isosteviol by Fusarium verticilloides. Phytochemistry 1996, 43, 393–395. [Google Scholar] [CrossRef]
- Parkinson, A.; Ogilvie, B.W.; Buckley, D.B.; Kazmi, F.; Czerwinski, M.; Parkinson, O. Chapter 6: Biotransformation of Xenobiotics. In Casarett & Doull’s Essentials of Toxicology, 3rd ed.; Klaassen, C.D., Watkins, J.B., Eds.; McGraw-Hill: New York, NY, USA, 2015; pp. 78–108. [Google Scholar]
- Lin, C.-L.; Lin, S.-J.; Huang, W.-J.; Ku, Y.-L.; Tsai, T.-H.; Hsu, F.-L. Novel ent-beyeran-19-oic acids from biotransformations of isosteviol metabolites by Mortierella isabellina. Planta Med. 2007, 73, 1581–1587. [Google Scholar] [CrossRef] [PubMed]
- Khan, M.R.; Doohan, F.M. Comparison of the efficacy of chitosan with that of a fluorescent pseudomonad for the control of Fusarium head blight disease of cereals and associated mycotoxin contamination of grain. Biol. Control 2009, 48, 48–54. [Google Scholar] [CrossRef]
- Kheiri, A.; Moosawi Jorf, S.A.; Malihipour, A.; Saremi, H.; Nikkhah, M. Application of chitosan and chitosan nanoparticles for the control of Fusarium head blight of wheat (Fusarium graminearum) in vitro and greenhouse. Int. J. Biol. Macromol. 2016, 93, 1261–1272. [Google Scholar] [CrossRef]
- Jeyakumar, J.M.J.; Zhang, M.; Thiruvengadam, M. Determination of mycotoxins by HPLC, LC-ESI-MS/MS, and MALDI-TOF MS in Fusarium species-infected sugarcane. Microb. Pathog. 2018, 123, 98–110. [Google Scholar] [CrossRef]
- Lozano-Ramírez, N.; Mezzalama, M.; Carballo-Carballo, A.; Hernández-Livera, A. Efectos de fungicidas en la calidad fisiológica de la semilla de trigo harinero (Triticum aestivum L.) y su eficacia en el control de Fusarium graminearum Schwabe [Gibberella zeae (Schwein.) Petch.] y Bipolaris sorokiniana (Sacc.) Shoemaker [Cochliobolus sativus S. Ito y Kurib.]. Rev. Mex. Fitopatol. 2006, 24, 115–121. [Google Scholar]
- Koch, E.; Weil, B.; Wächter, R.; Wohlleben, S.; Spiess, H.; Krauthausen, H.J. Evaluation of selected microbial strains and commercial alternative products as seed treatments for the control of Tilletia tritici, Fusarium culmorum, Drechslera graminea and D. teres. J. Plant Dis. Prot. 2016, 113, 150–158. [Google Scholar] [CrossRef]
- Schillinger, W.F.; Cook, R.J.; Papendick, R.I. Increased dryland cropping intensity with no-till barley. Agron. J. 1999, 91, 744–752. [Google Scholar] [CrossRef]
- Wang, M.; Sun, Y.; Gu, Z.; Wang, R.; Sun, G.; Zhu, C.; Guo, S.; Shen, Q. Nitrate protects cucumber plants against Fusarium oxysporum by regulating citrate exudation. Plant Cell Physiol. 2016, 57, 2001–2012. [Google Scholar] [CrossRef]
- Chen, Y.; Zhang, A.-F.; Gao, T.-C.; Zhang, Y.; Wang, W.-X.; Ding, K.-J.; Chen, L.; Sun, Z.; Fang, X.-Z.; Zhou, M.-G. Integrated use of pyraclostrobin and epoxiconazole for the control of Fusarium head blight of wheat in Anhui Province of China. Plant Dis. 2012, 96, 1495–1500. [Google Scholar] [CrossRef]

| Concentration (µg·mL−1) | Stevioside | Milk Thistle | Gallic Acid | Stevioside + Milk Thistle | Stevioside + Gallic Acid |
|---|---|---|---|---|---|
| EC50 | 155.92 ± 26.25 | 170.08 ± 22.82 | 150.16 ± 20.13 | 123.15 ± 14.79 | 125.33 ± 17.22 |
| EC90 | 221.01 ± 52.73 | 237.01 ± 42.74 | 228.94 ± 42.58 | 159.70 ± 24.64 | 160.03 ± 29.39 |
© 2020 by the authors. Licensee MDPI, Basel, Switzerland. This article is an open access article distributed under the terms and conditions of the Creative Commons Attribution (CC BY) license (http://creativecommons.org/licenses/by/4.0/).
Share and Cite
Buzón-Durán, L.; Martín-Gil, J.; Ramos-Sánchez, M.d.C.; Pérez-Lebeña, E.; Marcos-Robles, J.L.; Fombellida-Villafruela, Á.; Martín-Ramos, P. Antifungal Activity against Fusarium culmorum of Stevioside, Silybum marianum Seed Extracts, and Their Conjugate Complexes. Antibiotics 2020, 9, 440. https://doi.org/10.3390/antibiotics9080440
Buzón-Durán L, Martín-Gil J, Ramos-Sánchez MdC, Pérez-Lebeña E, Marcos-Robles JL, Fombellida-Villafruela Á, Martín-Ramos P. Antifungal Activity against Fusarium culmorum of Stevioside, Silybum marianum Seed Extracts, and Their Conjugate Complexes. Antibiotics. 2020; 9(8):440. https://doi.org/10.3390/antibiotics9080440
Chicago/Turabian StyleBuzón-Durán, Laura, Jesús Martín-Gil, María del Carmen Ramos-Sánchez, Eduardo Pérez-Lebeña, José Luis Marcos-Robles, Ángel Fombellida-Villafruela, and Pablo Martín-Ramos. 2020. "Antifungal Activity against Fusarium culmorum of Stevioside, Silybum marianum Seed Extracts, and Their Conjugate Complexes" Antibiotics 9, no. 8: 440. https://doi.org/10.3390/antibiotics9080440
APA StyleBuzón-Durán, L., Martín-Gil, J., Ramos-Sánchez, M. d. C., Pérez-Lebeña, E., Marcos-Robles, J. L., Fombellida-Villafruela, Á., & Martín-Ramos, P. (2020). Antifungal Activity against Fusarium culmorum of Stevioside, Silybum marianum Seed Extracts, and Their Conjugate Complexes. Antibiotics, 9(8), 440. https://doi.org/10.3390/antibiotics9080440

